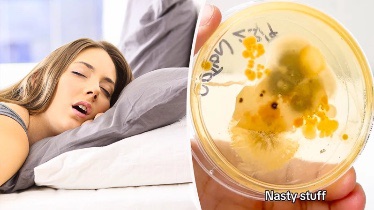

Έχουν υπάρξει φορές που βλέπετε τη μαξιλαροθήκη και σας πιάνει η αναβλητικότητα σε σημείο που λέτε “θα τη βάλω αύριο για πλύσιμο“;
- Νέα έρευνα θα σας κάνει να αλλάξετε γνώμη αν όχι να…χάσετε τον ύπνο σας σε περίπτωση που σκεφτείτε ξανά με τον ίδιο τρόπο.
Πάτα ΕΔΩ για τη συνέχεια…